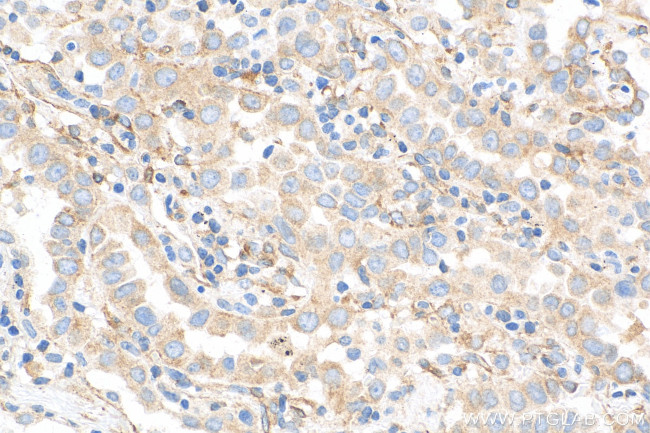
MAP4 Antibody in Immunohistochemistry (Paraffin) (IHC (P))

Search
Proteintech
MAP4 Monoclonal Antibody (1C1A6)
{{$productOrderCtrl.translations['antibody.pdp.commerceCard.promotion.promotions']}}
{{$productOrderCtrl.translations['antibody.pdp.commerceCard.promotion.viewpromo']}}
{{$productOrderCtrl.translations['antibody.pdp.commerceCard.promotion.promocode']}}: {{promo.promoCode}} {{promo.promoTitle}} {{promo.promoDescription}}. {{$productOrderCtrl.translations['antibody.pdp.commerceCard.promotion.learnmore']}}
产品信息
68271-1-IG
种属反应
宿主/亚型
分类
类型
克隆号
抗原
偶联物
形式
纯化类型
保存液
内含物
保存条件
运输条件
产品详细信息
Immunogen sequence: KSTQTVAKTT TAAAVASTGP SSRSPSTLLP KKPTAIKTEG KPAEVKKMTA KSVPADLSRP KSTSTSSMKK TTTLSGTAPA AGVVPSRVKA TPMPSRPSTT PFIDKKPTSA KPSSTTPRLS RLATNTSAPD LKNVRSKVGS TENIKHQPGG GRAKVEKKTE AAATTRKPES NAVTKTAGPI ASAQKQPAGK VQIVSKKVSY SHIQSKCGSK DNIKHVPGGG NVQIQNKKVD ISKVSSKCGS KANIKHKPGG GDVKIESQKL NFKEKAQAKV GSLDNVGHLP AGGAVKTEGG GSEAPLCPGP PAGEEPAISE AAPEAGAPTS ASGLNGHPTL SGGGDQREAQ TLDSQIQETS I
靶标信息
The protein encoded by this gene is a major non-neuronal microtubule-associated protein. This protein contains a domain similar to the microtubule-binding domains of neuronal microtubule-associated protein (MAP2) and microtubule-associated protein tau (MAPT/TAU). This protein promotes microtubule assembly, and has been shown to counteract destabilization of interphase microtubule catastrophe promotion. Cyclin B was found to interact with this protein, which targets cell division cycle 2 (CDC2) kinase to microtubules. The phosphorylation of this protein affects microtubule properties and cell cycle progression. Multiple transcript variants encoding different isoforms have been found for this gene. [provided by RefSeq].
仅用于科研。不用于诊断过程。未经明确授权不得转售。
篇参考文献 (0)
生物信息学
蛋白别名: MAP-4; Microtubule-associated protein 4
基因别名: MAP4
UniProt ID: (Human) P27816
Entrez Gene ID: (Human) 4134